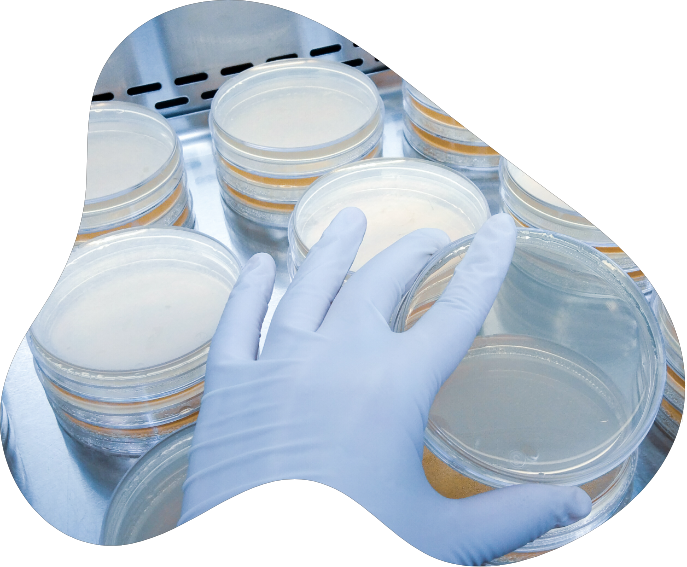
Group 3 Copy 16

We are a small family company, focused on the dairy industry, offering milk recording, laboratory and consultancy services to a range of clients from dairy farmers to multinational companies.
About us
Where quality counts
We benefit from over 50 years combined experience in the dairy sector and are also involved at the ‘cutting edge’ of mastitis research and the application of the latest findings on farm. We have an uncompromising approach to quality, throughout our business from milk recording to bacteriology, adopted from a firm research base.
QMMS has a dedicated team of personnel, including specialist veterinary surgeons, bacteriologists, and research assistants. Familiarity with farming and the industry as well as speaking to the same person ensures your query is dealt with rapidly and to your satisfaction.